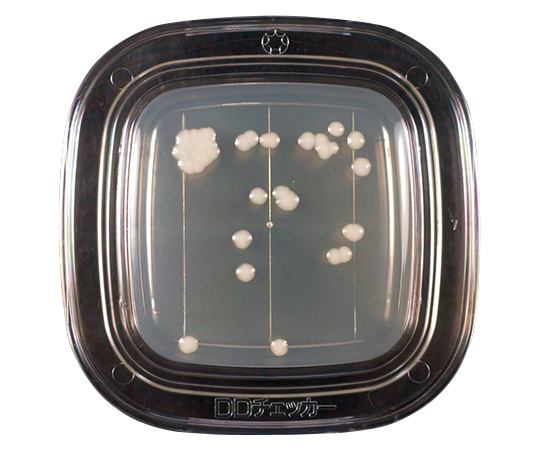

| Airis1.co.jp | 414-9542-776 |
|---|---|
| JANコード | 4987551042900 |
| アズワン | 6-8778-13 |
| 旧アイリスコード | D-1660-24 |
| 消費税区分 | 標準税率(10%) |
|
6,617円(税込) ※実際の消費税は消費税区分別にて算出されます |
極東製薬工業
PD寒天 No.410573(20枚×2箱)
商品 冷蔵品
特徴
スタンプ方式ですので、操作が容易です。
一般細菌検出用は発色液を使用する事により高感度に菌を検出する事ができ、最短8時間培養で当日中に判定できます。
各種の菌を選択的に検出できます。
仕様
培地名:PD寒天培地
タイプ:真菌検出用(CP加)
備考
※保存方法:2~10°C(遮光)、有効期間:DD寒天培地/製造より6ヶ月間、MBCP寒天培地/製造より3ヶ月間、その他/製造より4ヶ月間
個人宅宛の配送について
※配送先が個人宅宛の場合、 ご注文のキャンセル又は出荷まで+3営業日ほどお時間をいただく場合がございます。
| 商品コード | 414-9542-776 |
|---|---|
| ブランド | 極東製薬工業 |
| 型番 | No.410573 |
| 入数 | 20枚×2箱 |
| 標準価格 | |
| 割引率 | -384円 (6%) |
| WEB価格 | 6,016円(税抜) |
| 在庫数 | 取寄品 |
| 出荷目安 | 10日 |
ショッピングカート